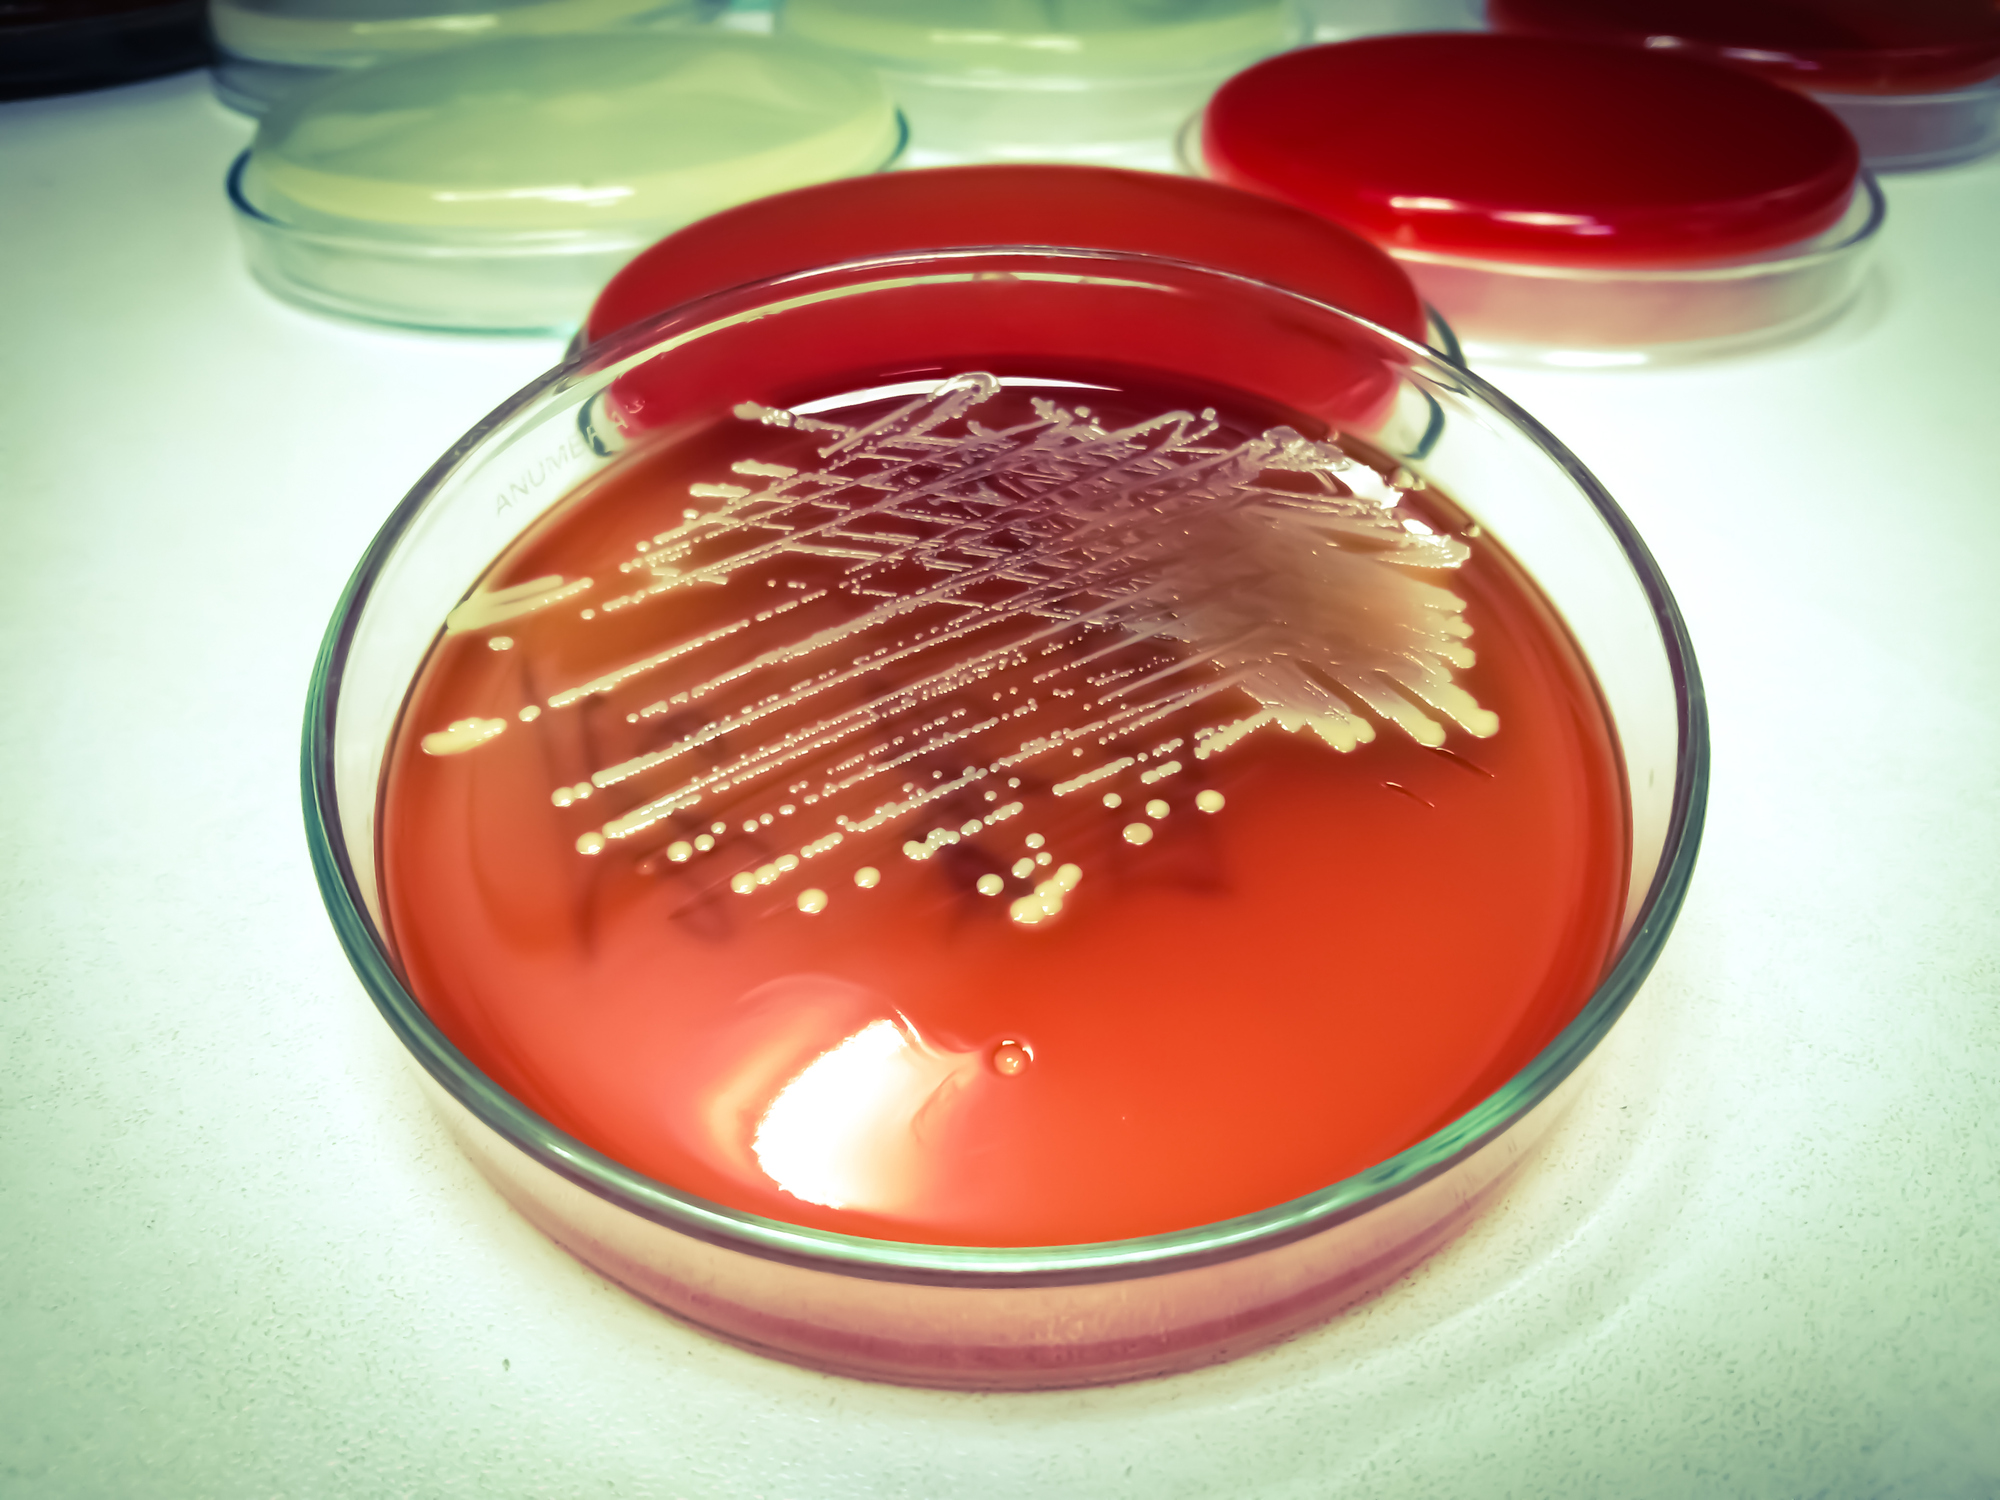

Test Gut Microbiome Health via Stool Culture (GP3 & GP3x)
Optimal gut microbiome health assessment requires both breadth and precision. The DiagnosTechs Bacterial Stool Culture (GP3) and Expanded Bacterial Stool Culture (GP3x) tests combine expansive detection capabilities with clinically focused reporting to deliver a deeper, more actionable understanding of gut health.
By identifying viable organisms and emphasizing those most relevant to patient care, the GP3 and GP3x tests bridge the gap between complex data and practical clinical insight.
Rather than overwhelming providers with lengthy reports filled with extensive lists of negative findings, these tests focus on what matters most: reporting the organisms that are present, viable, and clinically relevant.
Bacterial Stool Culture – Commonly Reported Organisms
The following organisms are the most frequently identified:
- Aeromonas spp.
- Alloscardovia spp.
- Arcobacter butzleri
- Bacillus altitudinis
- Bacillus pumilus
- Campylobacter spp.
- Carnobacterium spp.
- Citrobacter amalonaticus
- Citrobacter braakii
- Citrobacter farmeri
- Citrobacter freundii
- Citrobacter gillenii
- Citrobacter koseri
- Citrobacter murliniae
- Citrobacter youngae
- C. difficile
- Clostridioides spp.
- Clostridium halophilum
- Clostridium tertium
- Comamonas kerstersii
- Comamonas testosteroni
- Corynebacterium amycolatum
- Corynebacterium aurimucosum
- Corynebacterium minutissimum
- Cronobacter sakazakii
- Enterobacter aerogenes
- Enterobacter asburiae
- Enterobacter cloacae
- Enterobacter kobei
- Enterobacter ludwigii
- Enterococcus avium
- Enterococcus casseliflavus
- Enterococcus durans
- Enterococcus faecalis
- Enterococcus faecium
- Enterococcus gallinarum
- Enterococcus hirae
- Enterococcus mundtii
- Enterococcus raffinosus
- Escherichia coli
- Escherichia hermannii
- Hafnia alvei
- Hafnia paralvei
- Herbaspirillum aquaticum / H. huttiense
- Klebsiella oxytoca
- Klebsiella pneumoniae
- Klebsiella variicola
- Kluyvera ascorbata
- Kluyvera cryocrescens
- Lactobacillus murinus
- Lactobacillus rhamnosus
- Lactococcus garvieae
- Lactococcus lactis
- Leuconostoc lactis
- Leuconostoc pseudomesenteroides
- Lysinibacillus fusiformis
- Morganella morganii
- Neisseria perflava
- Proteus mirabilis
- Proteus penneri
- Proteus vulgaris
- Providencia rettgeri
- Pseudomonas aeruginosa
- Pseudomonas citronellolis
- Pseudomonas fluorescens
- Pseudomonas fragi
- Pseudomonas lundensis
- Pseudomonas mendocina
- Pseudomonas monteilii
- Pseudomonas nitroreducens
- Pseudomonas putida
- Pseudomonas rhodesiae
- Raoultella ornithinolytica
- Raoultella planticola
- Rothia mucilaginosa
- Salmonella spp.
- Serratia liquefaciens
- Serratia marcescens
- Shigella spp.
- Stenotrophomonas maltophilia
- Staphylococcus aureus
- Staphylococcus condimenti
- Staphylococcus epidermidis
- Staphylococcus simulans
- Streptococcus agalactiae
- Streptococcus anginosus
- Streptococcus canis
- Streptococcus constellatus
- Streptococcus cristatus
- Streptococcus dysgalactiae
- Streptococcus equi
- Streptococcus equinus
- Streptococcus gallolyticus
- Streptococcus gordonii
- Streptococcus infantarius
- Streptococcus lutetiensis
- Streptococcus mitis
- Streptococcus oralis
- Streptococcus parasanguinis
- Streptococcus peroris
- Streptococcus pneumoniae
- Streptococcus pyogenes
- Streptococcus salivarius
- Streptococcus sanguinis
- Streptococcus vestibularis
- Vibrio spp.
- Weissella confusa
- Weissella cibaria
- Weissella viridescens
- Yersinia spp.
More information is available in the Bacterial Stool Culture Interpretive Guide. The GP3 and GP3x tests included with DiagnosTechs’ GI Health Panels may also report additional organisms not listed in the interpretive guide, such as Bacillus megaterium and Lysinibacillus xylanilyticus.
Why Choose GP3 & GP3x Stool Culture Over PCR?
The number of organisms that can be reported via a GP3 pr GP3x Bacterial Stool Culture is nearly unlimited, while a PCR stool test is limited to reporting the one, specific organism tested.
Furthermore, when a bacterial pathogen is detected, DiagnosTechs can confirm clinical sensitivity to specific antibiotics, which is not possible with PCR methodology.
Advantages of Culture-Based Testing:
The GP3 and GP3x stool culture methods offer several important advantages:
- Broad detection capability: The number of organisms that can be identified is effectively unlimited, unlike PCR panels, which are restricted to predefined targets.
- Clinical relevance: Reports emphasize organisms that are actively growing and potentially clinically significant.
- Antibiotic sensitivity testing: When a bacterial pathogen is detected, susceptibility testing can be performed – an option not available with standard PCR testing.
Comprehensive Gut Health Testing – Stool Culture & Beyond
Consider combining the GP3 or GP3x Bacterial Stool Culture with stool microscopy (parasitology), antibody testing, the stool culture for yeast, and other tests to cast a much wider “diagnostic net” with a comprehensive GI Health Panel. The DiagnosTechs GI Health Panels test for ova and parasites, yeast overgrowth, bacterial pathogens, overgrowth of opportunistic bacterial pathogens, food sensitivities, inflammatory biomarkers, gut function markers, and more.
The DiagnosTechs GI Health Panels include EIA, microscopy, stool culture, and MALDI-TOF proteomic identification. With this technology, DiagnosTechs reports a wider range of pathogens than many laboratories, while also screening for systemic (extraintestinal) infections via unique saliva antibody tests.
These Provider Tools list the most commonly reported organisms:
- Complete GI Parasite List
- Complete Yeast Culture List
- Bacterial Stool Culture Interpretive Guide
- Bacterial Stool Culture Interpretation – Webinar Notes
The GI Health panels are listed on Page 4 of the Test & Fee Schedule. In addition, many of the individual GI Health Panel stool tests can be ordered with saliva hormone tests, including cortisol, testosterone, and insulin, using a Flexi-Matrix Combo test kit.
Clinical Support
DiagnosTechs’ Medical Support team is available via email and consultation to help determine the most appropriate GI Health Panel or individual tests based on each patient’s clinical presentation and diagnostic goals.